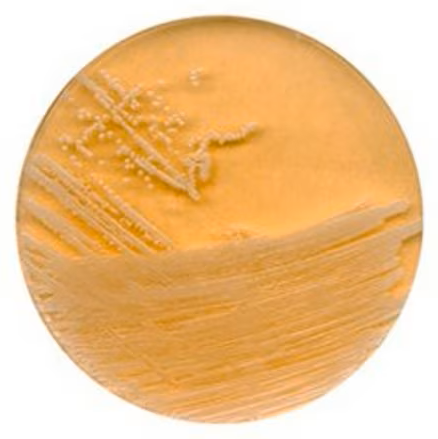
BD_BBL™_Sanitizer_Neutralizing_Agar_IC‑XT_Pack_gotowa_pożywka_na_płytkach_RODAC™_z_zamknięciem_10x10szt._Argenta_Bestlabs

BD BBL™ Sanitizer Neutralizing Agar IC-XT Pack gotowa pożywka na płytkach RODAC™ z zamknięciem 10x10szt.
•Kod produktu: 257617
•Ilość: 10x10 sztuk
 Opis
Opis
BD BBL™ Sanitizer Neutralizing Agar, IC-XT RODAC™ LL - kod producenta 257617
Kluczowe cechy
- Sterylny, gotowy do posiewu agar neutralizujący w formacie RODAC™ z blokowaną pokrywą LL - bezpieczny transport i ograniczenie ryzyka kontaminacji.
- Formuła do monitoringu po dezynfekcji: lecytyna, polisorbat 80, tiosiarczan sodu, pirogronian sodu, L-histydyna - wiarygodna analiza próbek z powierzchni krytycznych.
- IC-XT Pack - sterylizacja gamma, potrójne opakowanie z saszetką SORB-IT™ - zgodność z USP, EP i ISO 11137 dla pracy w izolatorach i pomieszczeniach czystych.
- Warunki przechowywania 2-25°C, typowy odzysk >70% - powtarzalność i precyzyjne pomiary w rutynowej kontrola jakości.
- Specyfikacja podłoża na 1 l: tryptozowy hydrolizat kazeiny 15 g, hydrolizat soi 5 g, NaCl 5 g, lecytyna 0,7 g, polisorbat 80 5 g, tiosiarczan 0,5 g, pirogronian 3,5 g, L-histydyna 1 g, agar 18,5 g.
- Pakowanie: 100 płytek w zestawach po 10 sztuk - efektywna obsada inkubatorów, łatwe trendowanie wyników.
Zastosowanie
BD BBL™ Sanitizer Neutralizing Agar przeznaczony jest do replikacyjnego wykrywania i zliczania mikroorganizmów, które przeżyły zabieg dezynfekcji w obszarach GMP. Neutralizacja pozostałości biocydów ogranicza wyniki zaniżone i wspiera audytowalne decyzje w laboratoria badawcze oraz działach QA. Płytki RODAC™ z blokadą ułatwiają pobór z powierzchni produkcyjnych, a zakres inkubacji 20-25°C lub 30-35°C dostosowuje metodę do celu badania. Rozwiązanie stanowi kluczowe wyposażenie laboratoryjne i uzupełnia sprzęt biotechnologiczny w kontroli środowiska, walidacji mycia oraz badaniach bioburden, zapewniając spójność SOP i zgodność z HACCP - co przekłada się na szybszą, rzetelną analiza próbek.
Becton Dickinson and Company to światowy lider w produkcji materiałów laboratoryjnych i diagnostycznych. Kod producenta dla tego produktu to: 257617.
 Koszty dostawy
Cena netto, nie zawiera podatku
Koszty dostawy
Cena netto, nie zawiera podatku
darmowa i wygodna wysyłka
już od 800 zł netto
Najwyższa jakość
produktów potwierdzona certyfikatami
Zakupy 24h na dobę
wygodne i bezpieczne
bezpłatna konsultacja
z ekspertem online